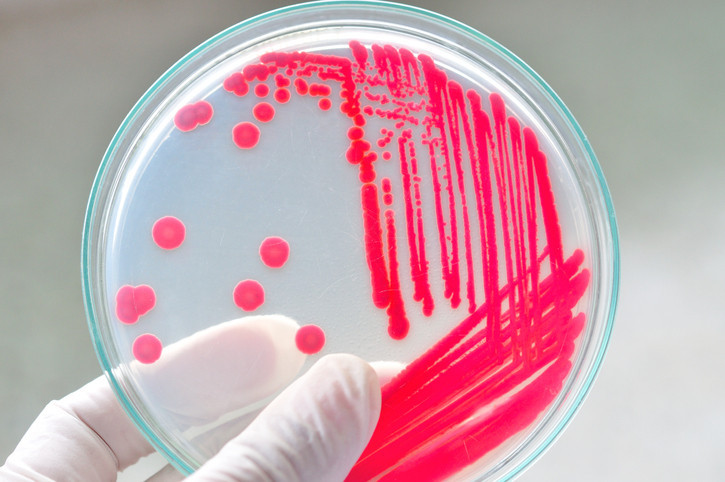

Harvard Health Blog
Read posts from experts at Harvard Health Publishing covering a variety of health topics and perspectives on medical news.
If you’re looking for gifts to give or donate, climate-conscious gifts come in many guises and fit no-cost, low-cost, or big budgets. Gifts can directly support the environment, trim waste and fossil fuel use, or offer creative ways to connect, reuse, recyle — and possibly regift.
Most people want to live at home for as long as possible as they age, and managing this successfully may mean hiring outside help. Considering this step raises many questions, and answering them honestly will help guide decisions about when and how to proceed.
Thousands of miles of veins throughout the body bring blood to the lungs to pick up oxygen and nutrients, and get rid of carbon dioxide before returning to the heart to be pumped out again. How do veins work, what problems can occur, and how can you keep these vital blood vessels healthy?
Formula companies claim that toddler formulas, also known as “follow-up formulas,” “transition formulas,” or “growing-up milks” offer nutritional benefits to toddlers. But are these products necessary and healthy?
In the US, more people seem to be seeking out the assistance of a doula when preparing to give birth. While such services may not be covered by insurance, a professional doula can provide emotional and physical support during pregnancy and throughout the birthing process.
Cellulitis, a skin infection that often occurs on the lower leg, develops when bacteria enter the body through a cut, bite, or other wound. A new study shows key aspects of healing typically occur within 10 days of treatment, but symptoms can linger for some time after that.
The typical American diet isn’t very healthy, and dietary shortfalls are more pronounced among people living in lower-income neighborhoods. A study analyzing data from produce prescription programs suggests that improving access to fresh vegetables and fruits may improve heart health.
Many people experience a decline in their driving skills as they age. While some choose to stop driving, others resist. Whether it’s you or a loved one, planning ahead can help you tackle fixable issues, make transitions easier, and avoid harming yourself or someone else.
Navigating whether or when an older person should limit or stop driving is tricky. Whether these concerns are about a family member or yourself, it’s helpful to be aware of red flags and to understand how driving abilities –– and risk for motor vehicle accidents –– change with age.
Headaches are very common in children and teens. We don’t tend to think about children getting migraines, but by age 10 one in 20 children has had one. Symptoms may differ from adults and it’s important for parents to understand triggers, helpful treatments, and possible red flags.
Virtually everyone carries the bacteria Clostridioides difficile, or C. diff. But half a million Americans a year develop a serious C. diff infection due to a gut microbiome imbalance. It disproportionately strikes people in hospitals and nursing homes, and can recur repeatedly.
Just how many hours of sleep are enough for you? The answer varies and it might be better to track sleep quality than focus on the number of hours you log each night.
A transurethral resection of the prostate is considered the gold-standard treatment for benign prostatic hyperplasia. But newer, less invasive procedures offer faster recovery times and fewer risks of complications. Earlier this year another new procedure won the FDA’s approval.
The human body has excess capacity — that is, our organs have more reserve than most of us will ever need. Why are we built with this natural redundancy? And which body parts can safely fail or be removed without impairing health?
Type 2 diabetes is a major cause of vision loss and blindness, kidney failure requiring dialysis, heart attacks, strokes, amputations, infections, and even early death. Research suggests that a healthy lifestyle can prevent diabetes from occurring in the first place, and even reverse its progress.
A high intake of sugar is linked to an increased risk of obesity, type 2 diabetes, cardiovascular disease, and certain cancers. But whether some sugars are healthier (or worse) than others remains a question of interest to many.
When news of the world is overwhelming and awful, our first instinct is usually to shelter our children and not say anything about it to them at all, a strategy that’s usually not viable. Instead parents can give children the perspective and skills they need to navigate a sometimes scary world.
Merkel cell cancer is a rare form of skin cancer that often spreads aggressively to other areas of the body. Here’s what to know about it, including who is more likely to get it and how you can take steps to help prevent it.
A common form of eczema called atopic dermatitis can interfere with daily activities. There are a number of prescription creams available to ease this chronic skin condition, but some are more effective than others, and a recent study compared them.
The human body has hundreds of lymph nodes, one part of the immune system that helps defend the body against health threats. They aren’t usually noticeable, but they are always working to deal with potential health problems.
Diabetes is a condition in which both high and low glucose levels are harmful to the body. In older individuals with multiple risk factors for hypoglycemia, the goal should be the best blood sugar control that can be achieved without putting the individual at risk for dangerously low blood sugar.
For people who have risk factors for heart disease, it’s important to make lifestyle changes like losing weight, getting more exercise, and eating a healthier diet. Longstanding habits are hard to change, but managing the challenge of healthy eating is easier if people have a partner who is supportive and involved in making food choices.
Many people mistakenly believe their headaches are due to sinus problems when actual reason is migraine. In reality, more than 85% of people who suspect that they have sinus headaches in fact have migraines.